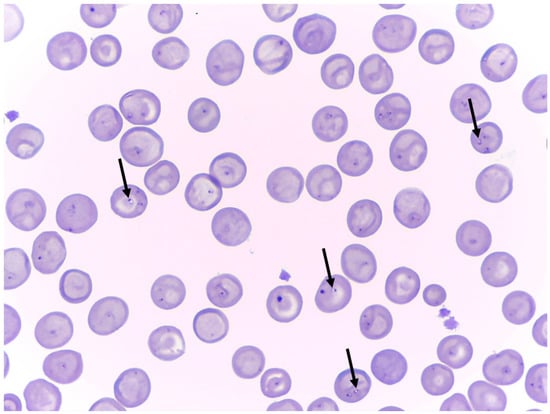

Abstract
Babesia vulpes is a small Babesia prevalent in foxes in Europe and mainly clinically affects dogs in north-western Spain. A dog imported from this region that had been living in Germany for three years developed splenic torsion. After splenectomy, the dog underwent immunosuppressive therapy because of autoimmune disease due to haemotrophic Mycoplasma sp. infection. As clinical signs worsened, small Babesia were detected in a blood smear and identified as B. vulpes by molecular analysis. Anaemia, thrombocytosis, elevated liver enzymes, and renal parameters were the most significant findings in blood analysis. The dog was treated with a combination of atovaquone (20 mg/kg BW, BID), proguanil hydrochloride (8 mg/kg BW, BID) and azithromycin (10 mg/kg BW, SID), which led to an increase in the cycle threshold in real-time PCR and the absence of B. vulpes in the blood smear. However, after clinical signs deteriorated, the dog was euthanised. This case report supports the recommendation to screen imported dogs for pathogens and highlights the impact of splenectomy on the course of infection.
1. Introduction
Babesia spp. are primarily transmitted by hard ticks and affect the red blood cells of a broad range of hosts. In dogs, Babesia spp. are classified as large or small Babesia based on their size. In Europe, B. canis is the most common species in dogs. Other large Babesia include B. vogeli, which occurs in the Mediterranean region, and B. rossi, which has been reported from Africa and is not autochthonous in Europe. Small Babesia include B. gibsoni, which may also be transmitted by non-vector routes, B. conradae, which has been reported in California, and B. vulpes [1,2].
For B. vulpes, Ixodes hexagonus is suspected to act as vector, but transmission studies confirming this are lacking [3,4]. Babesia vulpes has been found in red foxes (Vulpes vulpes). It has a high prevalence in many countries in Europe, indicating that foxes may be the reservoirs for this parasite [4,5,6,7,8,9,10,11,12,13,14,15]. Frequent clinical cases in dogs have been reported mainly in north-western Spain, but sporadic cases have also been reported in other European countries, including Sweden, Russia, and Hungary [16,17,18,19,20,21,22]. Furthermore, case reports outside of Europe have been reported recently [23,24]. The first description of this parasite came from a dog that lived in Germany but travelled to north-western Spain [25].
Clinically affected dogs show fever, anorexia, apathy, severe anaemia, and haemoglobinuria due to haemolysis [16,26,27]. As with the other small Babesia, therapy is more complex compared to B. canis and often does not result in complete elimination of the pathogen. The recommended treatment protocol is the combination of azithromycin with either atovaquone or buparvaquone [28,29].
Immunosuppression, either drug-induced or due to an underlying disease, can also complicate the course of disease in various other parasitic infections, e.g., Toxoplasma gondii or Strongyloides stercoralis [30,31,32]. Impaired immune defence can also be caused by splenectomy, which is known to result in higher parasitaemia and more severe clinical signs in dogs infected with Babesia [33,34,35].
Here we report a rare case of B. vulpes infection in a splenectomised dog imported from Spain but living in Germany for three years.
2. Results
2.1. Case History
A spayed female of unknown breed was rescued by a veterinary student from Galicia, Spain, in July 2018 and subsequently adopted by a veterinarian in Germany. At that time, the dog’s age was estimated to be 10–13 years, and the dog’s weight was 23–25 kg. In June 2021, the dog had to be splenectomised due to splenic torsion. The recovery was without complications. In August 2021, inappetence was noticed, and the following day the dog was apathetic and showed tachypnoea. Sonographic examination of the abdomen was unremarkable, but haematology revealed anaemia and thrombocytosis (Figure 1: 9 September 2021), and haemotrophic Mycoplasma spp. were detected using rt-PCR (Mycoplasma haemocanis (cycle threshold [Ct]: 27.18) and Candidatus Mycoplasma haematoparvum (Ct: 26.12)). Immune-mediated haemolytic anaemia was suspected, and the dog was treated with two blood transfusions (250 mL) from two dogs that had never travelled outside Germany. Additionally, the dog received prednisone (2 mg/kg bodyweight (BW), once a day (SID), orally (p.o.), reduced to 1 mg/kg BW after 3 weeks, and stopped after two months; prednisolon—5 mg, cp-pharma, Burgdorf, Germany), doxycycline (5 mg/kg BW, twice a day (BID), p.o., for two months; Doxybactin®, Dechra, London, UK), cyclosporine (4.76 mg/kg BW, BID, p.o.; Sporimune®, Dechra, London, UK), and mycophenolate (10 mg/kg BW, BID, p.o.; Mycophenolatmofetil, Hexal, Holzkirchen, Germany). The dog clinically improved, and in October 2021, erythrocyte count was within reference limits (Figure 1: 16 October 2021), and rt-PCR for haemotrophic Mycoplasma spp. was negative. However, thrombocytosis was still present.

Figure 1.
Erythrocyte counts (a), thrombocyte counts (b), and cell counts of leucocytes (c) at examined time points. Each point represents the measured value of each time point, and dotted lines represent reference values. Dates in blue are time points where measurement was performed with the ProCyte One® Haematology Analyser (IDEXX, Vienna, Austria).
In December 2021, the condition of the dog worsened suddenly, and the dog showed haemorrhagic gastroenteritis and severe anaemia (Figure 1: 30 December 2021). Doxycycline and prednisone in the above-mentioned starting dose were once again administered additionally to cyclosporine and mycophenolate. Amoxicillin (15 mg/kg BW, s.c.; Duphomax® L.A., Zoetis, Delémont, Switzerland), metamizole (50 mg/kg BW, s.c.; Novaminsulfon, Dechra, London, UK), and maropitant (1 mg/kg BW, s.c.; VetEmex®, cp-pharma, Burgdorf, Germany) were given as supportive therapy. Two blood transfusions (250 mL) were administered, one from a dog that had never travelled outside Germany and one from a dog from Spain, which tested negative for Babesia spp. and B. vulpes by rt-PCR retrospectively, 3 weeks after application. In January 2022, a blood smear revealed the presence of small Babesia sp. (Figure 2), which was subsequently identified as B. vulpes by rt-PCR (Table 1: 6 January 2022), RFLP, and sequencing. The ELISA antibody test using B. canis antigen was negative at that time point. Erythrocyte count revealed marked anaemia, and liver enzymes were increased (Figure 1, Table 1: 6 January 2022). A combination compound (Malarone®, GlaxoSmithKline, London, UK) containing atovaquone (20 mg/kg BW, BID) and proguanil hydrochloride (8 mg/kg BW, BID), and azithromycin (10 mg/kg BW, SID; Zithromax®, Pfizer Cooperation GmbH; Vienna, Austria) was given p.o. for 10 days, with a one-day interruption due to severe side effects, including inappetence, vomitus, and abdominal pain. Maropitant (2 mg/kg BW, SID, p.o.; Cerenia®, Zoetis, Delémont, Switzerland) was given as supportive therapy. Cyclosporine and mycophenolate were continued, and prednisone was tapered. After two weeks, the dog’s condition markedly improved. Erythrocyte counts and Ct values in rt-PCR increased (Figure 1, Table 1: 22 January 2022), pointing toward decreasing organism numbers, although the thrombocyte count was markedly elevated. Another two weeks later, the blood smear was negative for B. vulpes and the ELISA test for antibodies against B. canis antigen switched to positive (Figure 1, Table 1: 12 February 2022). Liver enzymes were still elevated but lower than before; however, creatinine and urea were increased. Clinically the dog’s condition suddenly deteriorated, showing inappetence and haematochezia, and it had to be euthanised.
Figure 2.
Diff-Quick stained peripheral blood smear before treatment against Babesia vulpes. Black arrows indicate B. vulpes.

Table 1.
Results of cycle threshold (Ct) value of B. vulpes rt-PCR, test result (TR) value of ELISA antibody test, liver enzymes, creatinine, and urea from the blood analysis of three different time points.
2.2. Molecular Analysis
The rt-PCR was negative for several Babesia spp. (B. canis, B. vogeli, B. rossi, B. gibsoni, and B. conradae) but positive for B. vulpes at the three time points examined as the Ct value increased (Table 1). PCR-RFLP showed fragments of around 485, 139, and 111 bp (HinfI); and 452, 192, and 146 bp (TaqI) in length, which is expected for B. vulpes (Figure 3). Sequencing of an 801 bp long 18S rRNA gene fragment showed 100% identity to B. vulpes found in a red fox (Vulpes vulpes) from Spain (GenBank accession number: KT223483). The obtained sequence was deposited in GenBank (accession number: ON968708).

Figure 3.
Gel electrophoresis of PCR-RFLP 18S rRNA gene fragments. Lane 1 presents a 100 bp molecular weight marker, lanes 2 to 4 and lanes 5 to 7 present PCR-RFLP products digested with endonucleases HinfI and TaqI, respectively. Lanes 2, 3, 5, and 6 present samples of the patient from two different time points, and lanes 4 and 7 present a sample with B. canis as positive controls.
3. Discussion
As in other cases of splenectomised dogs with Babesia infection, the present case showed severe clinical signs and eventually had to be euthanised [34,36]. Cases of splenectomised dogs with B. canis, B. vogeli, and B. gibsoni infection have been reported [1,33,34,35,36,37], and even a case report of B. vulpes is present in the literature [1]. Furthermore, another similar case has recently been published from Germany, which represents the first putative autochthonous B. vulpes infection in Germany in a dog [38]. According to the dog’s owners, the eleven-year-old dog had never left the country except for a holiday visit to Denmark. In this case, the positive PCR for Babesia sp. was initially interpreted as B. canis infection, and only subsequent sequencing revealed that it was B. vulpes. However, neither an entry in GenBank, nor details on the amplified gene fragment, are available. Moreover, the origin and travel history rely solely on the information provided by the owner, so an autochthonous infection in Germany cannot be considered as confirmed [38].
Similarly to the present case, Tuttle et al. [39] reported a B. canis infection in a dog, which became clinically apparent after the dog was treated for 5 months with immunosuppressive therapy for a Bartonella vinsonii infection. In the present case, no retrospective detection of the pathogen was possible, as there were no archived samples available. Although foxes in Germany were found to be positive for B. vulpes, this dog most likely acquired the infection in north-western Spain, where most clinical cases in dogs are reported [14,15,16]. The dog was living in Germany for three years without showing clinical signs of infection; however, splenectomy and immunosuppressive drugs given for the treatment of suspected immune-mediated haemolytic anaemia probably led to the unrestrained proliferation of B. vulpes and subsequent clinical disease [33,35,36]. It is not clear why B. vulpes has a high prevalence in foxes in many European countries, but cases rarely occur in dogs outside north-western Spain. Differences in vector distribution or density of fox population might contribute to this [4,40]. Ixodes hexagonus is considered a likely candidate as a vector, and indeed, differences in the distribution are present [3,4]. In north-western Spain, 38.5% of ticks found on dogs were I. hexagonus [40]. In Germany, I. hexagonus is mainly found in foxes and hedgehogs (Erinaceus europaeus, E. roumanicus), but cases of dogs being infested have been reported [41,42]. Surveys on ticks collected from dogs revealed 1.2% of them are I. hexagonus in Switzerland, 0.4% are in Austria, and 8.8% are in north-eastern Germany [43,44,45]. Although present in both regions, the prevalence of dogs infested with I. hexagonus is significantly higher in north-western Spain. Ixodes hexagonus is found on nearly 40% of the dogs there, and B. vulpes is the predominant Babesia species in dogs in north-western Spain. In other regions, lower infestation rates with I. hexagonus and rare autochthonous cases of B. vulpes infection in dogs are reported. These observations support the hypothesis that I. hexagonus could be the vector [40]. However, the vector competence of this tick vector has to be confirmed in further studies. Which other factors contribute to the high infestation rates with I. hexagonus and B. vulpes among dogs in Spain, in contrast to other regions (including habitat, climate, wildlife reservoir, lifestyle of dogs, among others), should also be further investigated. Other transmission routes should also be evaluated in further studies.
Nevertheless, it seems theoretically possible to acquire infection with B. vulpes in Germany if contact with an infected vector should occur. Moreover, imported infections can lead to clinical disease even years later, if an event that favours parasite multiplication, such as splenectomy, occurs [14,15,36,38].
Thrombocytopenia is a common feature in infections with B. vulpes; however, this case showed marked thrombocytosis [16,20]. Splenectomy can result in thrombocytosis in dogs, but platelet counts usually return to normal levels within a few weeks after surgery [46,47]. Presumably, thrombocytosis was due to glucocorticoid treatment, as might also be the case for leucocytosis [48,49]. However, leucocytosis was markedly present when measured with the ProCyte One® Haematology Analyser. Whether this was true leucocytosis at that time point, and there was no marked leucocytosis at the other time points, or if the differences were due to the different machines that were used could not be conclusively clarified, because no blood samples were tested with both devices at the same time point.
Even though the laboratory findings were suggestive of an improvement of the infection, seen by the increase in the Ct value and the absence of organisms in blood smear, the dog had to be euthanised because clinical signs deteriorated. The damage to the liver and kidneys might have been too severe at that stage. This damage may be a sequela of haemolysis and could have been exacerbated by drug treatment [50,51]. Kidney disease is a common complication in infections with Babesia, and azotaemia was found to be significantly associated with death in dogs with B. vulpes infection [20,26,37].
4. Materials and Methods
At IDEXX Laboratories, blood smear, complete blood count, biochemistry panel, serological testing, and real-time PCR (rt-PCR) were performed. Complete blood count in clinic was performed with the ProCyte One® Haematology Analyser (IDEXX, Vienna, Austria), and a biochemistry panel was examined with the Catalyst One® Chemistry Analyser (IDEXX, Vienna, Austria). Serological testing was performed with an enzyme-linked immunosorbent assay (ELISA) test (Babesia-ELISA Dog, AFOSA GmbH, Berlin, Germany), detecting IgG antibodies according to the manufacturer’s instructions [52]. The rt-PCR was performed with a Qube MDx real-time analyser as described previously by Strobl et al. [53], with the following modification for B. vulpes: target gene was cytochrome c oxidase subunit I gene, and for haemotrophic mycoplasma (Mycoplasma haemocanis and Candidatus Mycoplasma haematoparvum), the 16S ribosomal RNA gene.
At the University of Veterinary Medicine Vienna, a combination of PCR and restriction fragment length polymorphism (PCR-RFLP) was adapted from the protocol described by René-Martellet et al. [54]. Briefly, nested PCR targeting a fragment of the 18S rRNA gene was performed using external primers BTF1/BTR1 and internal primers BTF2/BTR2 [55]. Adaptions were made to the reaction mixture, which contained 5 µL extracted DNA, 2 µL forward and reverse primers (10 pmol/µL), 0.25 µL Taq polymerase (5 u/µL, GoTaq® G2 DNA Polymerase, Promega, Madison, WI, USA), 0.4 µL deoxyribonucleotides (25 mM), 10 µL reaction buffer, and 30.35 µL nuclease free water; and to the reaction temperature profile, which was 2 min at 94 °C for initial denaturation, followed by 40 cycles in the primary reaction or 35 cycles in the secondary reaction of 45 sec at 94 °C; 45 sec at 52 °C in the primary reaction or 62 °C in secondary reaction; 1 min at 72 °C; and 5 min at 72 °C as a final extension. PCR products were subsequently digested with the restriction enzymes HinfI and TaqI for RFLP and visualised by agarose gel electrophoresis. For Sanger sequencing, PCR products were sent to LGC Genomics and after aligning and trimming the primer-binding regions compared to GenBank entries using the blastn function.
5. Conclusions
Even in countries where clinical cases in dogs are still rare, B. vulpes should be added to the list of differential diagnoses if clinical signs are present, and imported dogs from endemic areas should be screened for relevant pathogens. Especially in splenectomised dogs, clinical signs caused by B. vulpes might recur, possibly enhanced by haemotrophic Mycoplasma spp. co-infections, and can result in a fatal outcome.
Author Contributions
Conceptualization, M.S.U., M.L., H.-P.F. and N.P.; methodology, M.S.U., M.L., H.-P.F. and N.P.; formal analysis, M.S.U., M.L., H.-P.F. and N.P.; investigation, M.S.U., N.P., C.B., K.W., M.G., A.R., H.-P.F. and M.L.; resources, H.-P.F. and N.P.; data curation, M.S.U., N.P., C.B., K.W., M.G., A.R. and H.-P.F.; writing—original draft preparation, M.S.U.; writing—review and editing, M.L. and N.P.; visualization, M.S.U., N.P., C.B., K.W. and M.G.; supervision, M.L. and H.-P.F. All authors have read and agreed to the published version of the manuscript.
Funding
This research received no external funding.
Institutional Review Board Statement
Ethical review and approval were waived for this study due to the circumstance that it is a case report where the samples were taken for medical reasons.
Informed Consent Statement
Not applicable.
Data Availability Statement
Additional data can be provided on request.
Acknowledgments
The authors would like to thank Bita Shahi-Barogh and Licha N. Wortha for their help with the laboratory work.
Conflicts of Interest
The authors declare no conflict of interest.
References
- Solano-Gallego, L.; Sainz, Á.; Roura, X.; Estrada-Peña, A.; Miró, G. A review of canine babesiosis: The European perspective. Parasit. Vectors 2016, 9, 336. [Google Scholar] [CrossRef] [PubMed]
- Baneth, G.; Cardoso, L.; Brilhante-Simões, P.; Schnittger, L. Establishment of Babesia vulpes n. sp. (Apicomplexa: Babesiidae), a piroplasmid species pathogenic for domestic dogs. Parasit. Vectors 2019, 12, 129. [Google Scholar] [CrossRef] [PubMed]
- Camacho, A.T.; Pallas, E.; Gestal, J.J.; Guitián, F.J.; Olmeda, A.S.; Telford, S.R.; Spielman, A. Ixodes hexagonus is the main candidate as vector of Theileria annae in northwest Spain. Vet. Parasitol. 2003, 112, 157–163. [Google Scholar] [CrossRef]
- Checa, R.; López-Beceiro, A.M.; Montoya, A.; Barrera, J.P.; Ortega, N.; Gálvez, R.; Marino, V.; González, J.; Olmeda, Á.S.; Fidalgo, L.E.; et al. Babesia microti-like piroplasm (syn. Babesia vulpes) infection in red foxes (Vulpes vulpes) in NW Spain (Galicia) and its relationship with Ixodes hexagonus. Vet. Parasitol. 2018, 252, 22–28. [Google Scholar] [CrossRef] [PubMed]
- Bartley, P.M.; Hamilton, C.; Wilson, C.; Innes, E.A.; Katzer, F. Detection of Babesia annae DNA in lung exudate samples from Red foxes (Vulpes vulpes) in Great Britain. Parasit. Vectors 2016, 9, 84. [Google Scholar] [CrossRef] [PubMed]
- Mierzejewska, E.J.; Dwużnik, D.; Koczwarska, J.; Stańczak, Ł.; Opalińska, P.; Krokowska-Paluszak, M.; Wierzbicka, A.; Górecki, G.; Bajer, A. The red fox (Vulpes vulpes), a possible reservoir of Babesia vulpes, B. canis and Hepatozoon canis and its association with the tick Dermacentor reticulatus occurrence. Ticks Tick Borne Dis. 2021, 12, 101551. [Google Scholar] [CrossRef]
- Santoro, M.; Auriemma, C.; Lucibelli, M.G.; Borriello, G.; D’Alessio, N.; Sgroi, G.; Veneziano, V.; Galiero, G.; Fusco, G. Molecular Detection of Babesia spp. (Apicomplexa: Piroplasma) in Free-Ranging Canids and Mustelids from Southern Italy. Front. Vet. Sci. 2019, 6, 269. [Google Scholar] [CrossRef]
- Battisti, E.; Zanet, S.; Khalili, S.; Trisciuoglio, A.; Hertel, B.; Ferroglio, E. Molecular Survey on Vector-Borne Pathogens in Alpine Wild Carnivorans. Front. Vet. Sci. 2020, 7, 1. [Google Scholar] [CrossRef]
- Duscher, G.G.; Fuehrer, H.-P.; Kübber-Heiss, A. Fox on the run—Molecular surveillance of fox blood and tissue for the occurrence of tick-borne pathogens in Austria. Parasit. Vectors 2014, 7, 521. [Google Scholar] [CrossRef]
- Hodžić, A.; Mrowietz, N.; Cézanne, R.; Bruckschwaiger, P.; Punz, S.; Habler, V.E.; Tomsik, V.; Lazar, J.; Duscher, G.G.; Glawischnig, W.; et al. Occurrence and diversity of arthropod-transmitted pathogens in red foxes (Vulpes vulpes) in western Austria, and possible vertical (transplacental) transmission of Hepatozoon canis. Parasitology 2018, 145, 335–344. [Google Scholar] [CrossRef]
- Cardoso, L.; Cortes, H.C.E.; Reis, A.; Rodrigues, P.; Simões, M.; Lopes, A.P.; Vila-Viçosa, M.J.; Talmi-Frank, D.; Eyal, O.; Solano-Gallego, L.; et al. Prevalence of Babesia microti-like infection in red foxes (Vulpes vulpes) from Portugal. Vet. Parasitol. 2013, 196, 90–95. [Google Scholar] [CrossRef]
- Koneval, M.; Miterpáková, M.; Hurníková, Z.; Blaňarová, L.; Víchová, B. Neglected intravascular pathogens, Babesia vulpes and haemotropic Mycoplasma spp. in European red fox (Vulpes vulpes) population. Vet. Parasitol. 2017, 243, 176–182. [Google Scholar] [CrossRef] [PubMed]
- Dezdek, D.; Vojta, L.; Curković, S.; Lipej, Z.; Mihaljević, Z.; Cvetnić, Z.; Beck, R. Molecular detection of Theileria annae and Hepatozoon canis in foxes (Vulpes vulpes) in Croatia. Vet. Parasitol. 2010, 172, 333–336. [Google Scholar] [CrossRef] [PubMed]
- Liesner, J.M.; Krücken, J.; Schaper, R.; Pachnicke, S.; Kohn, B.; Müller, E.; Schulze, C.; Samson-Himmelstjerna, G. von. Vector-borne pathogens in dogs and red foxes from the federal state of Brandenburg, Germany. Vet. Parasitol. 2016, 224, 44–51. [Google Scholar] [CrossRef] [PubMed]
- Najm, N.-A.; Meyer-Kayser, E.; Hoffmann, L.; Herb, I.; Fensterer, V.; Pfister, K.; Silaghi, C. A molecular survey of Babesia spp. and Theileria spp. in red foxes (Vulpes vulpes) and their ticks from Thuringia, Germany. Ticks Tick Borne Dis. 2014, 5, 386–391. [Google Scholar] [CrossRef]
- Miró, G.; Checa, R.; Paparini, A.; Ortega, N.; González-Fraga, J.L.; Gofton, A.; Bartolomé, A.; Montoya, A.; Gálvez, R.; Mayo, P.P.; et al. Theileria annae (syn. Babesia microti-like) infection in dogs in NW Spain detected using direct and indirect diagnostic techniques: Clinical report of 75 cases. Parasit. Vectors 2015, 8, 217. [Google Scholar] [CrossRef]
- Falkenö, U.; Tasker, S.; Osterman-Lind, E.; Tvedten, H.W. Theileria annae in a young Swedish dog. Acta Vet. Scand. 2013, 55, 50. [Google Scholar] [CrossRef]
- Radyuk, E.; Karan, L. A case of Babesia vulpes infection in a dog in Russia. Vet. Parasitol. Reg. Stud. Rep. 2020, 22, 100467. [Google Scholar] [CrossRef]
- Tuska-Szalay, B.; Vizi, Z.; Hofmann-Lehmann, R.; Vajdovich, P.; Takács, N.; Meli, M.L.; Farkas, R.; Stummer-Knyihár, V.; Jerzsele, Á.; Kontschán, J.; et al. Babesia gibsoni emerging with high prevalence and co-infections in “fighting dogs” in Hungary. Curr. Res. Parasitol. Vector Borne Dis. 2021, 1, 100048. [Google Scholar] [CrossRef]
- Camacho, A.T.; Pallas, E.; Gestal, J.J.; Guitián, F.J.; Olmeda, A.S.; Goethert, H.K.; Telford, S.R. Infection of dogs in north-west Spain with a Babesia microti-like agent. Vet. Rec. 2001, 149, 552–555. [Google Scholar] [CrossRef]
- Yisaschar-Mekuzas, Y.; Jaffe, C.L.; Pastor, J.; Cardoso, L.; Baneth, G. Identification of Babesia species infecting dogs using reverse line blot hybridization for six canine piroplasms, and evaluation of co-infection by other vector-borne pathogens. Vet. Parasitol. 2013, 191, 367–373. [Google Scholar] [CrossRef] [PubMed]
- Simões, P.B.; Cardoso, L.; Araújo, M.; Yisaschar-Mekuzas, Y.; Baneth, G. Babesiosis due to the canine Babesia microti-like small piroplasm in dogs-first report from Portugal and possible vertical transmission. Parasit. Vectors 2011, 4, 50. [Google Scholar] [CrossRef]
- Barash, N.R.; Thomas, B.; Birkenheuer, A.J.; Breitschwerdt, E.B.; Lemler, E.; Qurollo, B.A. Prevalence of Babesia spp. and clinical characteristics of Babesia vulpes infections in North American dogs. J. Vet. Intern. Med. 2019, 33, 2075–2081. [Google Scholar] [CrossRef] [PubMed]
- Arsenault, A.C.; Foley, P.M.; Clancey, N.P. Babesia vulpes in a dog from Prince Edward Island, Canada. Can. Vet. J. 2022, 63, 589–592. [Google Scholar] [PubMed]
- Zahler, M.; Rinder, H.; Schein, E.; Gothe, R. Detection of a new pathogenic Babesia microti-like species in dogs. Vet. Parasitol. 2000, 89, 241–248. [Google Scholar] [CrossRef]
- Camacho, A.T.; Guitian, F.J.; Pallas, E.; Gestal, J.J.; Olmeda, A.S.; Goethert, H.K.; Telford, S.R.; Spielman, A. Azotemia and Mortality among Babesia microti-Like Infected Dogs. J. Vet. Intern. Med. 2004, 18, 141. [Google Scholar] [CrossRef]
- Guitián, F.J.; Camacho, A.T.; Telford, S.R. Case–control study of canine infection by a newly recognised Babesia microti-like piroplasm. Prev. Vet. Med. 2003, 61, 137–145. [Google Scholar] [CrossRef] [PubMed]
- Baneth, G. Antiprotozoal treatment of canine babesiosis. Vet. Parasitol. 2018, 254, 58–63. [Google Scholar] [CrossRef] [PubMed]
- Checa, R.; Montoya, A.; Ortega, N.; González-Fraga, J.L.; Bartolomé, A.; Gálvez, R.; Marino, V.; Miró, G. Efficacy, safety and tolerance of imidocarb dipropionate versus atovaquone or buparvaquone plus azithromycin used to treat sick dogs naturally infected with the Babesia microti-like piroplasm. Parasit. Vectors 2017, 10, 145. [Google Scholar] [CrossRef]
- Paradies, P.; Iarussi, F.; Sasanelli, M.; Capogna, A.; Lia, R.P.; Zucca, D.; Greco, B.; Cantacessi, C.; Otranto, D. Occurrence of strongyloidiasis in privately owned and sheltered dogs: Clinical presentation and treatment outcome. Parasit. Vectors 2017, 10, 345. [Google Scholar] [CrossRef]
- Dubey, J.P.; Murata, F.H.A.; Cerqueira-Cézar, C.K.; Kwok, O.C.H.; Yang, Y.; Su, C. Toxoplasma gondii infections in dogs: 2009–2020. Vet. Parasitol. 2020, 287, 109223. [Google Scholar] [CrossRef] [PubMed]
- Chappell, L.H.; Wastling, J.M. Cyclosporin A: Antiparasite drug, modulator of the host-parasite relationship and immunosuppressant. Parasitology 1992, 105, S25–S40. [Google Scholar] [CrossRef] [PubMed]
- Máthé, A.; Vörös, K.; Németh, T.; Biksi, I.; Hetyey, C.; Manczur, F.; Tekes, L. Clinicopathological changes and effect of imidocarb therapy in dogs experimentally infected with Babesia canis. Acta Vet. Hung. 2006, 54, 19–33. [Google Scholar] [CrossRef] [PubMed]
- Camacho, A.T.; Pallas, E.; Gestal, J.J.; Guitián, F.J.; Olmeda, A.S. Babesia canis infection in a splenectomized dog. Bull. Soc. Pathol. Exot. 2001, 94, 17–19. [Google Scholar]
- Sikorski, L.E.; Birkenheuer, A.J.; Holowaychuk, M.K.; McCleary-Wheeler, A.L.; Davis, J.M.; Littman, M.P. Babesiosis caused by a large Babesia species in 7 immunocompromised dogs. J. Vet. Intern. Med. 2010, 24, 127–131. [Google Scholar] [CrossRef]
- Trotta, M.; Carli, E.; Novari, G.; Furlanello, T.; Solano-Gallego, L. Clinicopathological findings, molecular detection and characterization of Babesia gibsoni infection in a sick dog from Italy. Vet. Parasitol. 2009, 165, 318–322. [Google Scholar] [CrossRef]
- Wozniak, E.J.; Barr, B.C.; Thomford, J.W.; Yamane, I.; McDonough, S.P.; Moore, P.F.; Naydan, D.; Robinson, T.W.; Conrad, P.A. Clinical, Anatomic, and Immunopathologic Characterization of Babesia gibsoni Infection in the Domestic Dog (Canis familiaris). J. Parasitol. 1997, 83, 692. [Google Scholar] [CrossRef]
- Jetschin, S.; Bitter, V.; Neiger, R. Babesia vulpes-Infektion bei einem Hund in Deutschland—Mögliche Übertragungswege. Kleintierpraxis 2022, 67, 250–258. [Google Scholar] [CrossRef]
- Tuttle, A.D.; Birkenheuer, A.J.; Juopperi, T.; Levy, M.G.; Breitschwerdt, E.B. Concurrent bartonellosis and babesiosis in a dog with persistent thrombocytopenia. J. Am. Vet. Med. Assoc. 2003, 223, 1306–1310. [Google Scholar] [CrossRef]
- Checa, R.; Fidalgo, L.E.; Montoya, A.; López, A.M.; Barrera, J.P.; Gálvez, R.; La Sánchez de Nieta, S.; Marino, V.; Sarquis, J.; Miró, G. The role of healthy dog carriers of Babesia microti-like piroplasms. Parasit. Vectors 2019, 12, 127. [Google Scholar] [CrossRef]
- Kahl, O.; Bulling, I.; Chitimia-Dobler, L. Some new findings on the endophilic vector tick Ixodes hexagonus in Germany. Ticks Tick Borne Dis. 2022, 13, 101954. [Google Scholar] [CrossRef] [PubMed]
- Rubel, F.; Brugger, K.; Chitimia-Dobler, L.; Dautel, H.; Meyer-Kayser, E.; Kahl, O. Atlas of ticks (Acari: Argasidae, Ixodidae) in Germany. Exp. Appl. Acarol. 2021, 84, 183–214. [Google Scholar] [CrossRef] [PubMed]
- Duscher, G.G.; Feiler, A.; Leschnik, M.; Joachim, A. Seasonal and spatial distribution of ixodid tick species feeding on naturally infested dogs from Eastern Austria and the influence of acaricides/repellents on these parameters. Parasit. Vectors 2013, 6, 76. [Google Scholar] [CrossRef] [PubMed]
- Eichenberger, R.M.; Deplazes, P.; Mathis, A. Ticks on dogs and cats: A pet owner-based survey in a rural town in northeastern Switzerland. Ticks Tick Borne Dis. 2015, 6, 267–271. [Google Scholar] [CrossRef] [PubMed]
- Beck, S.; Schreiber, C.; Schein, E.; Krücken, J.; Baldermann, C.; Pachnicke, S.; von Samson-Himmelstjerna, G.; Kohn, B. Tick infestation and prophylaxis of dogs in northeastern Germany: A prospective study. Ticks Tick Borne Dis. 2014, 5, 336–342. [Google Scholar] [CrossRef] [PubMed]
- Woolcock, A.D.; Keenan, A.; Cheung, C.; Christian, J.A.; Moore, G.E. Thrombocytosis in 715 Dogs (2011–2015). J. Vet. Intern. Med. 2017, 31, 1691–1699. [Google Scholar] [CrossRef]
- Phipps, W.E.; de Laforcade, A.M.; Barton, B.A.; Berg, J. Postoperative thrombocytosis and thromboelastographic evidence of hypercoagulability in dogs undergoing splenectomy for splenic masses. J. Am. Vet. Med. Assoc. 2020, 256, 85–92. [Google Scholar] [CrossRef] [PubMed]
- Toroghi, N.; Abbasian, L.; Nourian, A.; Davoudi-Monfared, E.; Khalili, H.; Hasannezhad, M.; Ghiasvand, F.; Jafari, S.; Emadi-Kouchak, H.; Yekaninejad, M.S. Comparing efficacy and safety of different doses of dexamethasone in the treatment of COVID-19: A three-arm randomized clinical trial. Pharmacol. Rep. 2022, 74, 229–240. [Google Scholar] [CrossRef]
- Shoenfeld, Y.; Gurewich, Y.; Gallant, L.A.; Pinkhas, J. Prednisone-induced leukocytosis. Am. J. Med. 1981, 71, 773–778. [Google Scholar] [CrossRef]
- Schulz, B.S.; Hupfauer, S.; Ammer, H.; Sauter-Louis, C.; Hartmann, K. Suspected side effects of doxycycline use in dogs—A retrospective study of 386 cases. Vet. Rec. 2011, 169, 229. [Google Scholar] [CrossRef]
- van Avondt, K.; Nur, E.; Zeerleder, S. Mechanisms of haemolysis-induced kidney injury. Nat. Rev. Nephrol. 2019, 15, 671–692. [Google Scholar] [CrossRef] [PubMed]
- Pantchev, N.; Schnyder, M.; Vrhovec, M.G.; Schaper, R.; Tsachev, I. Current Surveys of the Seroprevalence of Borrelia burgdorferi, Ehrlichia canis, Anaplasma phagocytophilum, Leishmania infantum, Babesia canis, Angiostrongylus vasorum and Dirofilaria immitis in Dogs in Bulgaria. Parasitol. Res. 2015, 114, 117–130. [Google Scholar] [CrossRef] [PubMed]
- Strobl, A.; Pantchev, N.; Martin, L.; Guija-De-Arespacochaga, A.; Hinney, B.; Fuehrer, H.-P.; Leschnik, M. Co-infection with Babesia canis and Babesia gibsoni in a dog. Acta Vet. Hung. 2021, 69, 347–353. [Google Scholar] [CrossRef]
- René-Martellet, M.; Moro, C.V.; Chêne, J.; Bourdoiseau, G.; Chabanne, L.; Mavingui, P. Update on epidemiology of canine babesiosis in Southern France. BMC Vet. Res. 2015, 11, 223. [Google Scholar] [CrossRef]
- Jefferies, R.; Ryan, U.M.; Irwin, P.J. PCR-RFLP for the detection and differentiation of the canine piroplasm species and its use with filter paper-based technologies. Vet. Parasitol. 2007, 144, 20–27. [Google Scholar] [CrossRef]
Disclaimer/Publisher’s Note: The statements, opinions and data contained in all publications are solely those of the individual author(s) and contributor(s) and not of MDPI and/or the editor(s). MDPI and/or the editor(s) disclaim responsibility for any injury to people or property resulting from any ideas, methods, instructions or products referred to in the content. |
© 2023 by the authors. Licensee MDPI, Basel, Switzerland. This article is an open access article distributed under the terms and conditions of the Creative Commons Attribution (CC BY) license (https://creativecommons.org/licenses/by/4.0/).



